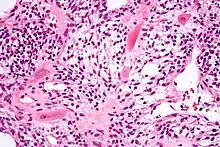

Intermediate trophoblast
Intermediate trophoblast is a distinct subtype of trophoblastic tissue that arises from the cytotrophoblast.[1]
Micrograph showing intermediate trophoblasts. H&E stain.

Implantation site intermediate trophoblast. Low molecular weight cytokeratin stain.
It is sub-categorized by location:[1]
- Villous intermediate trophoblast:
- at anchoring villi of trophoblastic column
- Implantation site intermediate trophoblast:
- at implantation site (or basal plate), differentiated from villous intermediate trophoblast
- Chorionic-type intermediate trophoblast
- at chorionic laeve of fetal membrane, differentiated from villous intermediate trophoblast
Function
The function of the implantation site intermediate trophoblast is to anchor the placenta to the maternal tissue.
Histomorphology
- Villous intermediate trophoblast[1]
- polyhedral and uniform nuclei
- prominent cell border; abundant eosinophilic to clear cytoplasm
- cohesive growth
- Implantation site intermediate trophoblast[1]
- pleomorphic irregular nuclei, large and hyperchromatic, may multinucleation
- abundant eosinophilic to amphophilic cytoplasm
- infiltrative growth (splitting muscle, replacing vascular wall ...etc)
- Chorionic-type intermediate trophoblast[1]
- round to polyhedral nuclei, may multinucleation
- abundant eosinophilic to clear cytoplasm
- cohesive growth
Pathology
Intermediate trophoblasts are thought to be the cell of origin for:[1]
- Exaggerated placental site (EPS): implantation site IT
- Placental site nodule (PSN): chorionic-type IT
- Placental site trophoblastic tumour (PSTT): implantation site IT
- Epithelioid trophoblastic tumour (ETT): chorionic-type IT
References
- Shih IM, Kurman RJ (January 2001). "The pathology of intermediate trophoblastic tumors and tumor-like lesions". Int. J. Gynecol. Pathol. 20 (1): 31–47. doi:10.1097/00004347-200101000-00004. PMID 11192071.
This article is issued from Wikipedia. The text is licensed under Creative Commons - Attribution - Sharealike. Additional terms may apply for the media files.